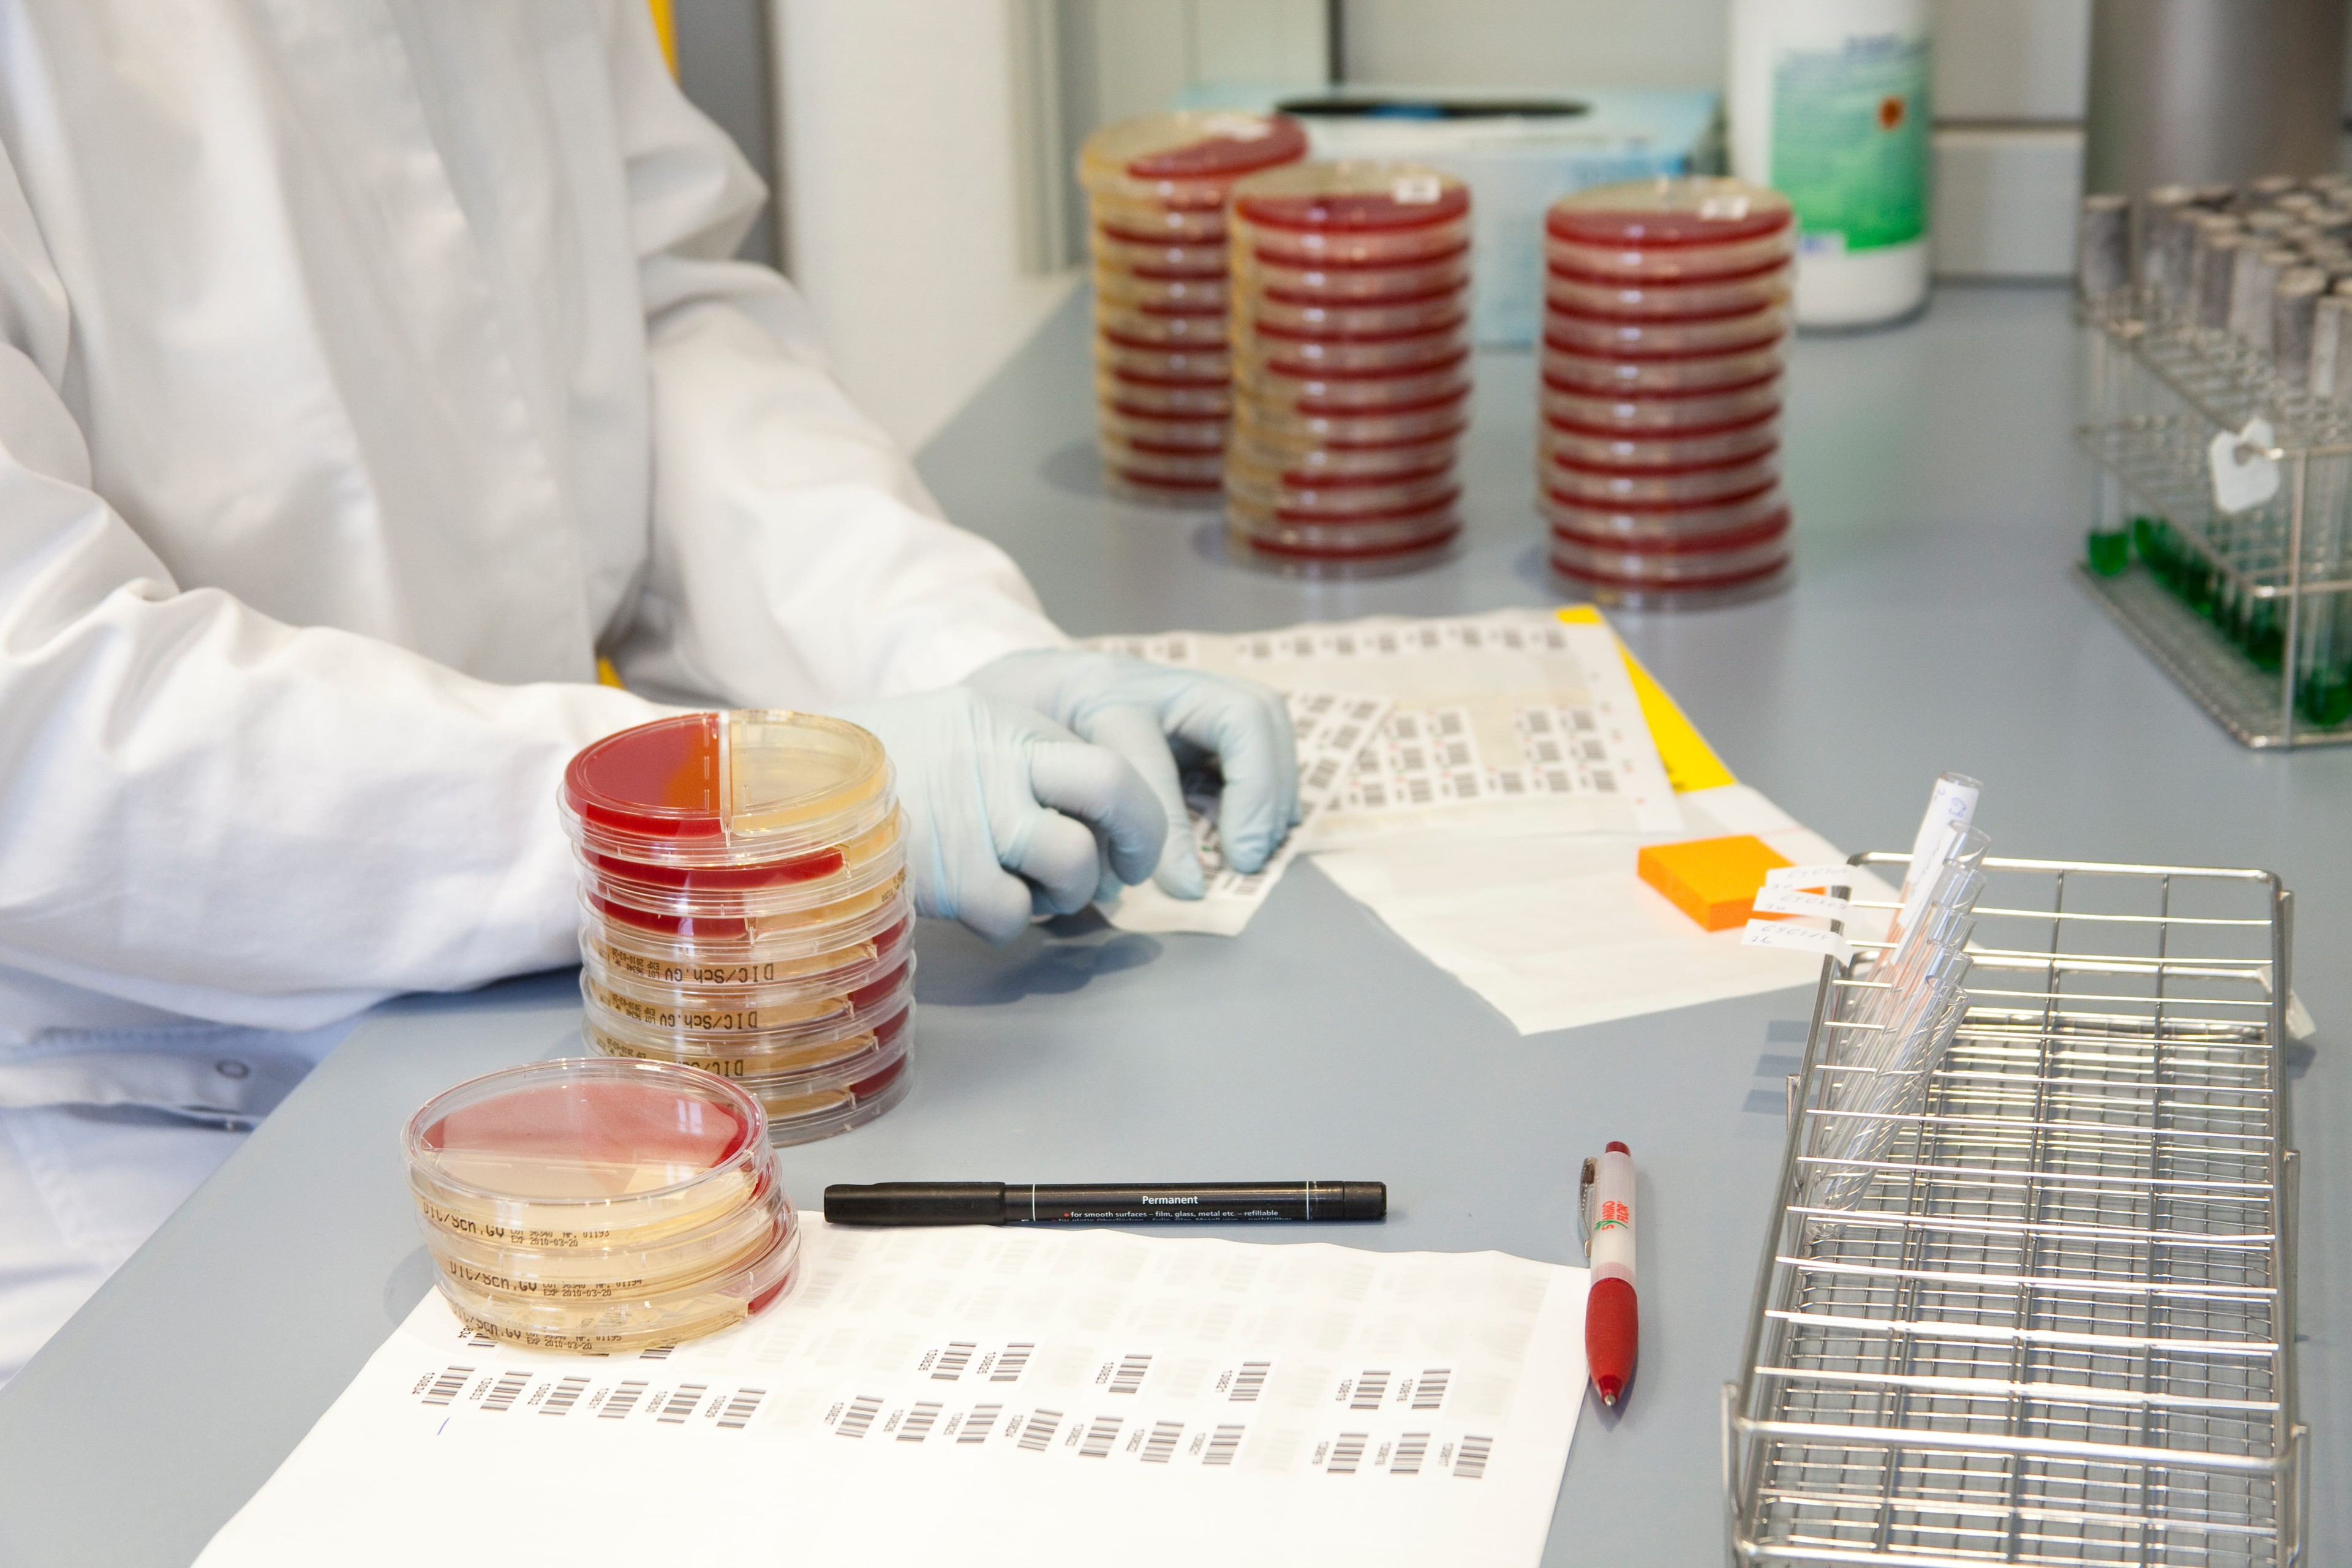

Pressemitteiung
Bildergalerie
Pressebilder für Ihre redaktionelle Berichterstattung

Die Bilder auf dieser Seite stellen wir Ihnen honorarfrei zur Verfügung. Bitte geben Sie bei Veröffentlichung die Bildquelle "MVZ Institut für Mikroökologie GmbH" an.
Laden Sie das Bild einfach über die Download-Funktion in druckfähiger Auflösung herunter.



Pressebilder
Haben Sie Fragen zu unserer Diagnostik, zum Mikrobiom oder damit assoziierten Erkrankungen? Wir helfen gerne weiter und vermitteln Ihnen Experten für Ihre Berichterstattung:
presse@mikrooek.de
Angelika Hecht: 02772-981-350
Ramona Ortmüller: 02772-981-204
Fax: 02772-981-151
MVZ Institut für Mikroökologie
Auf den Lüppen 8
35745 Herborn-Hörbach